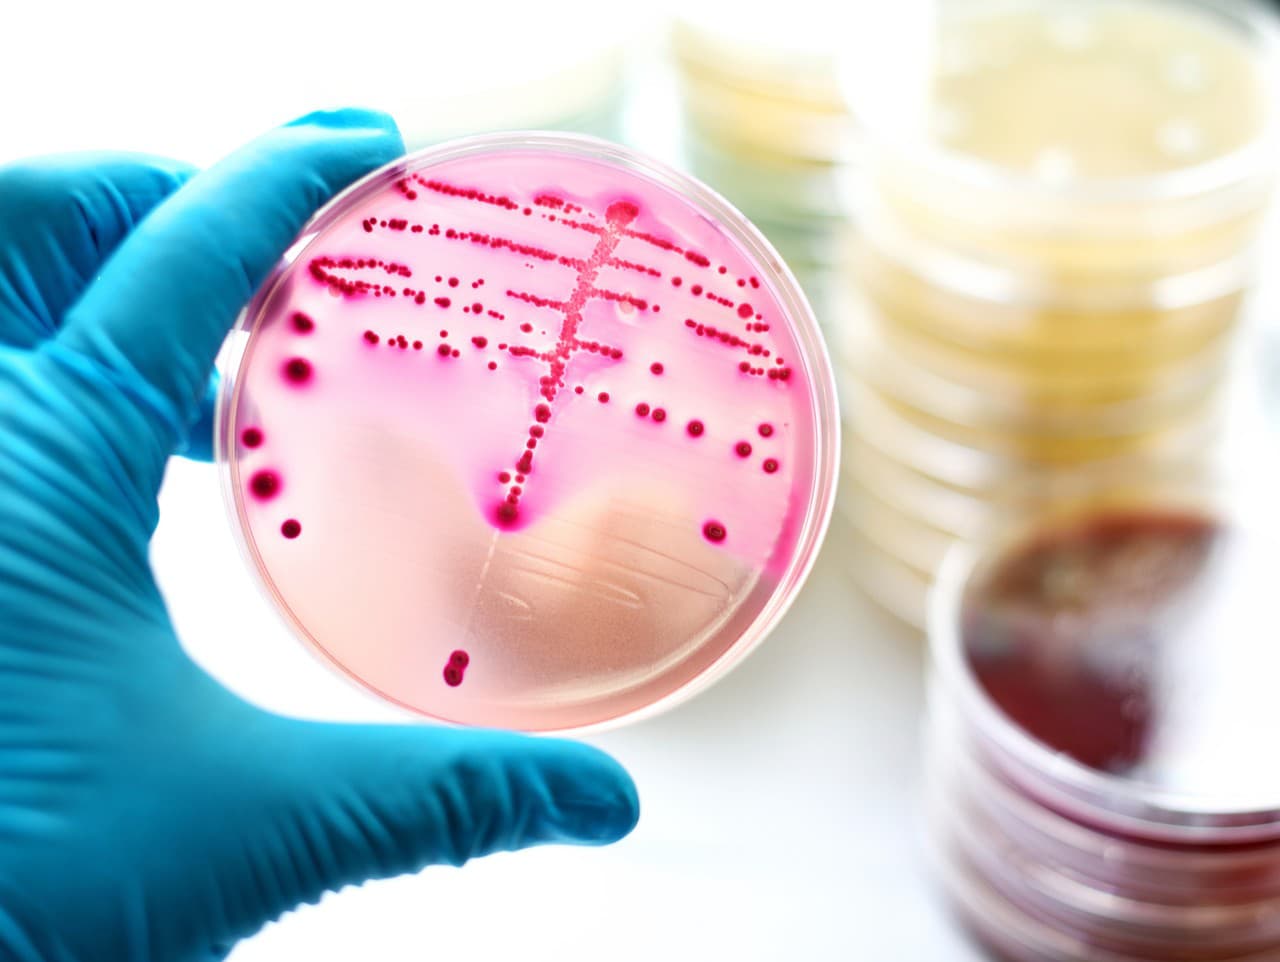
Ilustračný obrázok

WASHINGTON – Americké centrum pre kontrolu a prevenciu chorôb (CDC) zverejnilo šokujúcu štatistiku. Prípady život ohrozujúcich baktérií sa v USA od roku 2013 zdvojnásobili a počet úmrtí stúpol až na alarmujúcich 2000.
Hrozivé štatistiky boli zverejnené v prestížnom časopise Journal of the American Medical Association. Štúdia používala dáta z viac ako 10 štátov, no zistenia boli prekvapivé aj pre skúsených odborníkov. Celková incidencia sa zvýšila z 3,6 na 8,2 prípadov na 100 000 osôb a počet infekcií vzrástol z 1082 prípadov na 2759 prípadov v roku 2022, informuje Daily Star.
Zaznamenaných bolo viac ako 2000 úmrtí za celé deväťročné obdobie. Ako najviac alarmujúca je baktéria, ktorá požiera mäso. Výskyt tohto ochorenia bol obzvlášť vysoký medzi staršími ľuďmi nad 65 rokov, osobami v dlhodobej starostlivosti, ale aj medzi ľuďmi bez domova a užívateľmi drog.
Podľa odborníkov k hrozivým štatistikám prispieva aj rastúca miera cukrovky a obezity, čím sa niektorí ľudia stali náchylnejší aj na invazívne streptokoky. V Amerike sa šíri najmä baktéria Streptococcus pyogenes, ktorá patrí medzi invazívne infekcie. Šíri sa z človeka na človeka priamym kontaktom a to najmä sekrétmi z nosa, hrdla, či rán. Najnebezpečnejší je stav, keď baktéria vstúpi do krvi alebo hlbokého tkaniva, čo môže viesť až k život ohrozujúcemu ochoreniu. Medzi počiatočné príznaky patrí vysoká horúčka, silné bolesti, boľavé svaly, závraty a intenzívna červená vyrážka.
Vo Veľkej Británii zase bojujú s nárastom prípadov tuberkulózy, pričom v roku 2023 zaznamenali nárast až o 13%. Odborníci tvrdia, že ide o najväčší nárast od 70. rokov 20.storočia. Ochorenie spôsobuje baktéria Mycobacterium tuberculosis a šíri sa vzdušnými kvapôčkami. Liečiteľná je antibiotikami, no v prípade, že sa podcení, môže byť smrteľná.